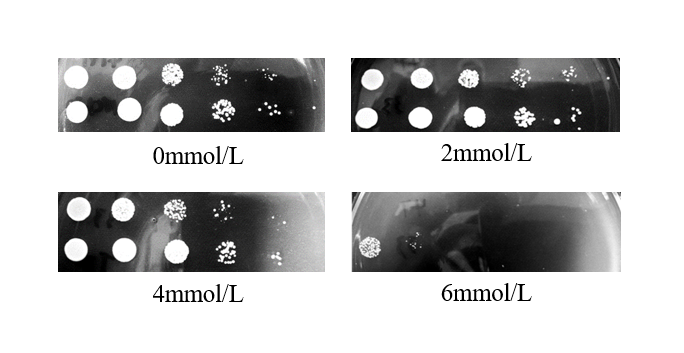

抗氧化酵母转录谱测序及初步分析毕业论文
2020-07-02 22:53:15
摘 要
酵母作为现代社会使用广泛、研究深入的真核生物,为人类社会贡献巨大。本文以一株抗氧化能力较好的酵母为研究对象,以对数初期加入4mmol/L H2O2 处理30min作为测序条件,对照组不加H2O2,提取总RNA并运用二代测序技术进行转录谱测序,对其结果进行分析,从整体上揭露氧化胁迫下酵母细胞的基因响应及代谢变化。本实验主要集中分析了过氧化物酶体、DNA修复、蛋白酶体以及葡糖糖代谢途径的变化。发现多条DNA修复途径均明显增强,过氧化物酶体内多个抗氧化酶基因转录水平发生明显差异,磷酸戊糖途径成为葡萄糖的主要代谢途径,蛋白酶体基因转录水平整体上调。另外还发现多个表达改变量超过四倍的未知功能基因。
关键词:活性氧 氧化应激 抗氧化 二代测序技术 转录谱测序
Sequencing and analysis of the transcriptional spectrum of antioxidant yeast
ABSTRACT
As a widely used and deeply researched eukaryotic organism, yeast has contributed greatly to the human society. In this paper, a yeast with good anti-oxidation ability was used as the research object. The initial logarithmic addition of 4mmol/L H2O2 for 30min was used as the sequencing condition. The control group was extracted without H2O2, and total RNA was extracted and second-generation sequencing technology was used for transcriptional sequencing. The results were analyzed to reveal the overall gene response and metabolic changes of yeast cells under oxidative stress. This experiment focused on the analysis of changes in peroxisomes, DNA repair, proteasomes, and glucose metabolism pathways. Multiple DNA repair pathways were found to be significantly enhanced, and the transcriptional levels of multiple antioxidant enzyme genes in peroxidases were significantly different. The pentose phosphate pathway became the main metabolic pathway for glucose, and the proteasome gene transcription levels were overall upregulated. In addition, a number of unknown functional genes with more than four-fold changes in expression were also found.
Key words: Reactive oxygen;Oxidative stress;anti-oxidation;Second-generation sequencing technology; Transcriptional profiling
目录
摘 要 I
ABSTRACT II
第一章 前 言 1
1.1引言 1
1.2自由基 1
1.3 ROS的产生 1
1.4自由基对大分子物质的损害 2
1.5 抗氧化系统 2
1.5.1酶系防御体系 3
1.6 转录组及转录组学 4
1.7二代测序技术 4
1.8研究意义 5
1.9 研究路线 5
第二章 材料与方法 6
2.1 材料 6
2.1.1菌株 6
2.1.2 培养基 6
2.1.3 主要仪器 6
2.1.4 主要试剂 7
2.2.1 菌体的活化 7
2.2.2 转录谱测序条件的选择 7
2.2.3 RNA的提取 8
2.2.4 Total RNA样品质量检测 8
2.2.5 转录组测序 9
2.2.6 GO富集分析与KEGG富集分析 9
第三章 结果 10
3.1转录谱测序条件的选择 10
3.2 RNA的提取 10
3.3 NCY-w33样品质量的检测 11
3.4 测序错误率分布检查 12
3.5参考序列的拼接及比对 13
3.6 RNA-seq样品间相关性检查 13
3.7基因表达水平统计表 14
3.8基因差异表达分析及差异基因筛选 14
3.9 GO与KEGG富集分析 15
3.9.1 DNA修复 17
3.9.2 蛋白酶体 17
3.9.3 葡萄糖代谢 18
3.9.4 过氧化物酶体 18
3.10表达差异倍数超过4的未知基因 19
第四章 结论与展望 20
4.1结论 20
4.2展望 20
参考文献 21
致谢 24
第一章 前 言
1.1引言
酵母是一种重要的兼性厌氧菌,单细胞生物,它在无氧环境与有氧环境均能生存[1]。大量细胞能够同时处于某一状态并同步接受实验条件,并且寿命较短,繁殖速度快,对生长环境的要求比较低。酵母的基因表达调控和信号转导机制与高等生物具有高度同源性[2]。酵母作为发酵工业中的主力军之一,应用广泛。这些特点使得酵母不仅是一个有用的模型体系,而且是一个重要的商业实体。因此,研究它的生物学、生理学、生物化学和遗传学具有多种实用意义。由于测序技术的的日益发展及研究的深入,酵母的模式菌全基因组测序已经完成,更加方便了对具有优良抗逆性的野生酵母进行基因挖掘[3]。氧化损伤是多种人类疾病的重要诱因之一,通过RNA-seq技术研究氧化胁迫下酵母转录谱的变化,我们也能够深入了解高等生物机体抵抗氧化损伤的分子机制。
1.2自由基
自由基是指那些含有不配对电子的独立存在的原子或基团,又被称为游离基(Free Radicals) [4]。这些自由基为了形成稳定,从其它正常分子或化合物夺取电子,这一过程导致被夺取电子基团形成新的自由基,因此这就形成一个恶性链锁循环反应。在正常情况下,机体内抗氧化系统使自由基维持在较低水平,但如果自由基的产生与清除的动态平衡被打破,就会导致机体内自由基大量堆积,这些自由基会造成组织器官水平、细胞水平及分子水平的损伤,从而加速机体的衰老进程[5]。随着医学水平的发展,人们确定众多老年疾病与氧化损伤存在直接联系,如阿尔茨海默病(Alzheimer disease ,AD)[6]、亨廷顿氏病[7]、多发性硬化[8]和帕金森病(Parkinson disease, PD)[9]等。
1.3 ROS的产生
对需氧真核生物而言,自用以维持细胞生命活动的能量有大约95%来自线粒体,但线粒体也是细胞内ROS的主要来源,会产生O2-和H2O2等。在细胞内,氧化活性最强的羟自由基(·OH)可以通过非酶促反应(如:芬顿反应)产生,过氧化氢(H2O2)与具有氧化还原能力的铁离子(铁硫蛋白等)就可以发生反应。线粒体在正常生理状况下会消耗1-5%的氧气产生ROS。产生的ROS还可通过电子传递并相互转化,从而形成更多种类的ROS。
1.4自由基对大分子物质的损害
自由基会使得核酸组成部分之间出现交联现象,从而影响核酸的正常功能,另外ROS会引起碱基错位及缺失,出现严重的不可逆损伤,最终导致细胞死亡。蛋白质的多肽链对直接或间接的受到自由基的攻击而发生断裂;而氨基酸也会受到自由基的影响而发生结构变化,最终会导致酶失活 [10]。同时它还极易攻击多不饱和脂肪酸,在经受自由基的破坏后会造成脂质过氧化物[11]。细胞功能紊乱就会在生物膜组织被破坏后出现[12]。多种有害的醛类物质也会被自脂质过氧化物降解出,如丙二醛(MDA)。而MDA会与DNA和蛋白质直接发生反应,导致DNA发生错配,蛋白质聚集。详情见图1-1。

相关图片展示: